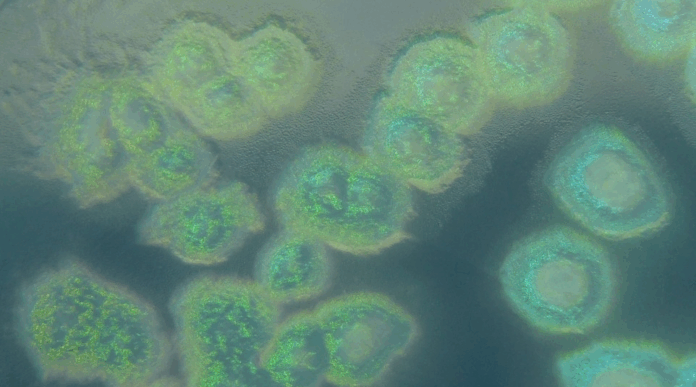

Investigadoras e investigadores del CSIC descubren comunidades bacterianas activas en un medio tóxico, abriendo nuevas posibilidades para la astrobiología y la biotecnología.
En un avance que desafía nuestras concepciones sobre los límites de la vida, un equipo internacional liderado por el Centro de Biología Molecular Severo Ochoa (CBM-CSIC-UAM) ha demostrado que ciertas bacterias no solo pueden sobrevivir, sino también adaptarse y proliferar durante más de 30 años en agua pesada ultra pura, un entorno extremadamente tóxico para la mayoría de las formas de vida conocidas.
El estudio, publicado en la revista Microbial Genomics, contó con la participación de investigadoras e investigadores de la Universidad Autónoma de Madrid, el Centro Nacional de Biotecnología (CNB-CSIC), el Instituto de Ciencia y Tecnología de Polímeros (ICTP-CSIC), el Laboratorio Subterráneo de Canfranc (LSC) y la Universidad de Tubinga, Alemania.
Un hallazgo inesperado en garrafas olvidadas
Las bacterias fueron descubiertas en garrafas de plástico herméticamente cerradas, que contenían agua pesada almacenada durante más de tres décadas en el Departamento de Física de Materiales de la UAM. A pesar de la ausencia total de nutrientes y de un entorno químicamente hostil —con enlaces moleculares más estables que dificultan las reacciones biológicas—, las muestras contenían millones de bacterias por mililitro.
A diferencia del agua común (H₂O), el agua pesada (D₂O) contiene deuterio, un isótopo del hidrógeno que interfiere con funciones celulares clave como la producción de energía y la estabilidad del ADN. Por eso, encontrar bacterias no solo vivas, sino metabólicamente activas en estas condiciones, representa un descubrimiento sin precedentes.
“No existen ambientes naturales en la Tierra con una concentración de deuterio tan alta como la de nuestras muestras, lo que convierte este hallazgo en una oportunidad única para estudiar nuevas formas de adaptación microbiana”, señaló Juan Rivas, investigador del CNB y autor del estudio.
Una deuterosfera microbiana
Mediante técnicas de secuenciación masiva y análisis metagenómicos, el equipo identificó comunidades bacterianas pertenecientes principalmente a las familias Pseudomonadota y Bacteroidota, conocidas por su resistencia y capacidad de adaptación a condiciones extremas.
Estas bacterias presentan rasgos genéticos únicos: genes más cortos, proteínas optimizadas para reducir el gasto energético y, sorprendentemente, genes asociados a la degradación del plástico (polietileno), lo que sugiere que podrían estar utilizando el propio envase como fuente de carbono.
“Este tipo de adaptaciones abre posibilidades fascinantes en biotecnología, especialmente en estrategias de reciclaje de plásticos resistentes”, comentó Francisco Sobrino, jefe de laboratorio en el CBM.
Además, se detectó una alta presencia de genes relacionados con la reparación y recombinación del ADN, lo que refuerza la hipótesis de que estas bacterias han desarrollado mecanismos sofisticados para mantener su integridad genética en un entorno que normalmente la comprometería.
Implicancias para la vida fuera de la Tierra
El estudio tiene importantes repercusiones para la astrobiología. “Lo que describimos como deuterosfera, un microambiente con alta concentración de deuterio, podría ser un modelo para explorar los límites de la vida en otros mundos”, explicó Ricardo Amils, microbiólogo del CBM y codirector del estudio.
Actualmente, el equipo desarrolla experimentos en el Laboratorio Subterráneo de Canfranc para observar cómo influye la ausencia de radiación cósmica en la evolución de estas bacterias, simulando condiciones similares a las de Marte o lunas heladas como Encélado y Europa.
Aunque el agua pesada no se ha detectado en grandes cantidades fuera de la Tierra, mediciones espaciales indican que ciertos cuerpos del sistema solar —como Venus, cometas y lunas heladas— presentan proporciones elevadas de deuterio, lo que refuerza la relevancia del modelo experimental.
Más allá de la Tierra: biotecnología y sostenibilidad
Este descubrimiento no solo amplía nuestra comprensión de la vida en condiciones extremas, sino que abre nuevas rutas para la biotecnología ambiental, incluyendo la degradación de plásticos en ambientes inusuales y la exploración de rutas metabólicas adaptadas a entornos artificiales como los de los reactores nucleares.
La capacidad de estas bacterias para transformar un medio tóxico en hábitat funcional redefine los márgenes de lo que consideramos “vida viable” y sugiere que aún queda mucho por descubrir sobre la diversidad metabólica y adaptativa del mundo microbiano.